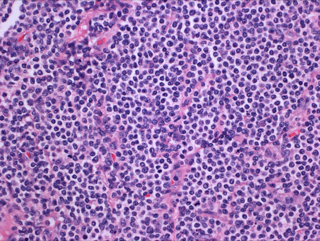

单形性亲上皮性肠道 T 细胞淋巴瘤
Monomorphic Epitheliotropic Intestinal T-Cell Lymphoma,MEITL
概述:
MEITL EATL 是一种原发性肠道淋巴瘤,来源于上皮内淋巴细胞。肿瘤由中等单一形态细胞组成,广泛浸润上皮,不伴其它炎性细胞,坏死也较少见。发病与乳糜泻无关。原为 2 型 EATL,WHO 2016 修改版将此型分出单独立为一类。
发病部位: 常见于小肠,胃、结肠罕见
诊断要点:
主要见于亚裔和西班牙裔,散发,无乳糜泻无病史。累及小肠,尤其是空肠。少见侵犯胃(5%)和结肠 16%)。就诊时常有肠系膜淋巴结肿大或已累及其它器官。临床表现为腹痛、肠梗阻、腹泻、体重下降等。
肿瘤细胞广泛侵润,具有明显亲上皮性,包括隐窝和表面肠上皮。肠绒毛变形、扩大。细胞中等大小,形态单一,核圆,染色质精细分散,无明显核仁,胞浆较淡相对较多。无混合炎性细胞,坏死也较 EATL 少。
免疫表型:绝大多数病例 CD3+、CD8+、CD56+、MATK+、TCR-γδ+(少数 TCR-β+),罕见 TCRgamma+/TCRbeta+,TIA1 也常阳性(但粒酶 B 和穿孔素常阴性)。CD5 阴性,EBV 阴性(可有散在 B 细胞阳性)。
TCR 基因克隆性重排阳性,STAT5B 突变阳性,大多数病例有 MYC 基因扩增,但 1 号和 5 号染色体扩增较 EATL 少见。其它常突变的基因有: JAK3. GNAI2. SETD2 等。

免疫组织化学染色:
CD3+、CD8+、CD56+、MATK+、TCR-γδ+(少数 TCR-β+)
分子标记:
TCR 基因克隆性重排阳性,STAT5B 突变阳性,大多数病例有 MYC 基因扩增,但 1 号和 5 号染色体扩增较 EATL 少见
鉴别诊断:
肠病相关 T 细胞淋巴瘤 (Enteropathy-Associated T-Cell Lymphoma, EATL):主要见于北欧人,与乳糜泻密切相关。肿瘤细胞中到大,广泛浸润肠壁和上皮,坏死常见。免疫表型:CD3+,CD7+,CD103+,细胞毒(如粒酶 B)+,TCR-β+ ,TCR-γδ-(偶有 +),CD8-/+,CD4-,CD5-,CD56-,CD30-/+(间变样细胞+)。多数病例有 1 号和 5 号染色体扩增,仅少数病例有 MYC 基因扩增。
结外 NK/T 细胞淋巴瘤,鼻型 :组织形态可类似 MEITL,肿瘤细胞常呈现血管中心性浸润,胞浆 CD3 阳性,EBER 阳性。
间变性大细胞淋巴瘤 (ALCL):罕见累及小肠,细胞大,异型明显,肿瘤细胞呈现均匀一致 CD30 强阳性,ALK+/-,EMA+/-。
成人 T 细胞白血病/淋巴瘤 (ATLL):可累及小肠和肠系膜淋巴结,组织形态学可与 MEITL 相似,但非肿瘤侵犯区小肠黏膜无乳糜泻样病理改变,肿瘤细胞 CD25 强阳性,血清学 HTLV-1 检测阳性。
消化道惰性 T 淋巴细胞增生性疾病 (Indolent T-cell Lymphoproliferative Disease of the Gastrointestinal Tract):WHO 20167 年版新增的临时疾病实体。发病年龄从青少年到老年(中位年龄 48 岁),表现为消化道症状(腹痛、腹泻、呕吐等)。病变可累及消化道任何部位(从口腔至大肠),表现为粘膜固有层小淋巴细胞致密侵润,偶延及粘膜肌层或粘膜下,肠上皮内很少有明显侵犯。 免疫表型:CD3+、CD5+、CD7+、CD8+/CD4-(少数 CD4+/CD8-)、TIA1+、TCR betaF1+、CD56-、TCR gamma-、EBER-。TCR 基因克隆性重组阳性,STAT3 SH2 突变阴性。临床病程惰性,长期无明显进展。
肠 T 细胞淋巴瘤- 非特指: 指发生于肠道(有时也包括消化道其它部位如胃)的 T 细胞淋巴瘤,在形态和免疫学上不符合 EATL 或 MEITL。有时给出这诊断,系由于标本不理想(如缺乏肠黏膜上皮部分)或免疫组化不完全。目前不认为这是一个特异的疾病实体。多数已报道的病例肿瘤 T 细胞为细胞毒表型。
预后:
预后差,中位生存期 7 个月。
← 蕈样霉菌病 T细胞幼淋巴细胞白血病 →
